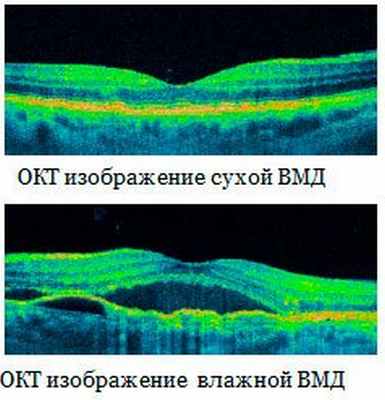

Возрастная макулярная дистрофия
Добавил пользователь Алексей Ф. Обновлено: 27.01.2026
Консультация офтальмолога БЕСПЛАТНО при удалении халязиона, новообразований (папиллом) век, инородных тел роговиц и конъюнктивы! (цена .
Скидки для друзей из социальных сетей!
Эта акция - для наших друзей в "Одноклассниках", "ВКонтакте", "Яндекс.Дзене", YouTube и Telegram! Если вы являетесь другом или подписчиком стр.
Для жителей районов Савеловский, Беговой, Аэропорт, Хорошевский
В этом месяце жителям районов Савеловский, Беговой, Аэропорт, Хорошевский» предоставляется скидка 5% на ВСЕ мед.
Ардамакова Алеся Валерьевна
Врач-офтальмолог, лазерный хирург
Кандидат медицинских наук
Никулина Ольга Васильевна
Мы в Telegram и "Одноклассниках"
Офтальмологические операции
"MediaMetrics", радиостанция, программа "Медицинские гаджеты" (ноябрь 2017г.)
Людям старше 50 лет нередко ставят диагноз «возрастная макулярная дегенерация» (ВМД). Что означают эти слова? Какую угрозу для зрения таит данный недуг?
ВМД - хроническое прогрессирующее дистрофическое заболевание центральной области сетчатки глаза (макулы), ведущее к постепенной потере центрального зрения, необходимого для четкого восприятия предметов.
Центральное зрение при возрастной макулярной дегенерации становится размытым, затуманенным, в центре поля зрения появляются темные пятна, очертания предметов искажаются, ухудшается восприятие цвета. При этом периферическое зрение сохраняется.

Возрастная макулярная дегенерация. Лечение

Возрастная макулярная дегенерация. Лечение

Возрастная макулярная дегенерация. Лечение
В связи с необратимым ухудшением зрения вплоть до слепоты среди людей старше 50 лет возрастная макулярная дегенерация (ВМД) сетчатки стала офтальмологической проблемой №1. Сегодня каждый пятый человек старшей возрастной подгруппы в развитых странах мира страдает от этого заболевания.
Причины развития макулярной дегенерации
Установлено, что заболеваемость ВМД увеличивается с возрастом старше 50 лет, но некоторые формы недуга могут развиться и у более молодых людей. При этом риск развития ВМД увеличивается троекратно, если это заболевание выявлялось у близких родственников.
Помимо возрастного и генетического факторов, на появление макулярной дегенерации влияют:
- половая принадлежность (женщины болеют в 2 раза чаще, чем мужчины);
- раса (подавляющее большинство больных - европейцы);
- высокий уровень холестерина;
- сосудистые поражения; ; ; ;
- лишний вес;
- курение;
- дефицит витаминов и антиоксидантов;
- пребывание под ультрафиолетовыми лучами без защитных очков.
Формы макулярной дегенерации
Макулярная дегенерация развивается в двух формах:
Сухая форма макулярной дегенерации
Это самая распространенная форма данной патологии, которая выявляется в 80-90% случаев. При этом заболевании лежащий под сетчаткой слой пигмента истончается, а со временем рассыпается и откладывается в виде небольших желтых комочков (друз) под пигментным эпителием.
Центральное зрение ухудшается постепенно, поэтому болезнь может бесконтрольно развиваться в течение нескольких лет.
Ежегодное посещение офтальмолога позволит отследить развитие патологического процесса на ранней стадии.

Возрастная макулярная дегенерация. Лечение

Возрастная макулярная дегенерация. Лечение

Возрастная макулярная дегенерация. Лечение
Влажная форма макулярной дегенерации
В некоторых случаях невылеченная сухая форма макулярной дегенерации переходит во влажную.
В то время как при сухой форме идут процессы атрофии, при влажной дегенерации начинается прорастание новообразованных сосудов (неоваскуляризация), берущих своё начало во внутренних слоях сосудистой оболочки, в образующееся (в норме отсутствующее) пространство под сетчаткой. Сквозь стенки этих новых сосудов вместе с жидкостью легко просачиваются клетки крови, затем они в большом количестве попадают в пространство под сетчаткой и там накапливаются, вызывая отек и кровоизлияние.
Это приводит светочувствительные клетки сетчатки к гибели, а в макуле начинают образовываться «слепые пятна».
Влажная форма ВМД характеризуется стремительным развитием воспалительного процесса и быстрой потерей центрального зрения.
В основе данной формы макулярной дегенерации лежит аномальный рост сосудов, т.е. хориоидальная неоваскуляризация (ХНВ). Организм ошибочно пытается создать новые сосуды для обеспечения питания клеток сетчатки глаза. Однако патологический процесс приводит к появлению рубцов и, в конечном итоге, к потере зрения.
Симптомы макулярной дегенерации
О возрастной макулярной дегенерации сетчатки говорят следующие признаки:
- появление в области центрального зрения пятна перед глазами;
- ослабление цветового восприятия;
- искажение предметов;
- расплывчатость, нечеткость изображения;
- сильное ухудшение сумеречного зрения.
Диагностика и лечение макулярной дегенерации сетчатки в клинике «МедикСити»
Диагностика макулярной дегенерации начинается в кабинете врача-офтальмолога со сбора анамнеза. Доктор выслушивает жалобы пациента и проводит обследование с помощью следующих диагностических методик:
- - исследование остроты центрального зрения; ; - диагностика глазного дна; - изучение состояния глазного дна и сетчатки.
В нашей клинике для изучения патологии сетчатки применяется один из самых точных и современных приборов - аппарат Spectralis HRA+OST.
С помощью флюоресцентной ангиографии глазного дна проводится динамическое наблюдение за состоянием пациентов, страдающих сухой формой макулярной дегенерации. После внутривенного введения контрастного вещества выполняются снимки срезов центральной оболочки сетчатки.
Оптическая когерентная томография применяется для выявления изменений сетчатки на самом раннем этапе заболевания.
Кроме того, с помощью данных методов можно контролировать эффективность проводимой терапии.
Лечение макулярной дегенерации
Несмотря на то, что полностью вылечить макулярную дегенерацию на сегодняшний день невозможно, существуют методы, помогающие добиться хороших результатов терапии на ранних этапах заболевания.
При сухой форме макулярной дегенерации для восстановления обменных процессов в сетчатке глаза рекомендуются курсы антиоксидантной терапии.
Терапия влажной формы заболевания направлена на подавление патологического роста сосудов.
В клинике «МедикСити» лечение сосудистых проблем, возрастных изменений и периферических дистрофических образований в сетчатке проводится на аппарате нового поколения - лазерном коагуляторе Supra.
Лечение с помощью лазера позволяет уничтожить патологические сосуды в сетчатке глаза и предупредить их дальнейшее образование.
Возрастная макулярная дегенерация

Возрастная макулярная дегенерация (ВМД) — одно из самых распространенных глазных заболеваний, являющееся основной причиной потери зрения у людей старше 40 лет. По данным Всемирной организации здравоохранения 161 миллион человек в мире страдают заболеваниями глаз, в том числе 25-30 миллионов человек поражены ВМД. В России заболеваемость возрастной макулярной дегенерацией составляет более 15 человек на 1000 населения, но до настоящего времени сохраняется большое количество (до 51.6%) россиян, которые никогда не слышали о ВМД (Исследование компании Bausch & Lomb по вопросу возрастной макулярной дегенерации 2007 года).
Пациенты с диагнозом ВМД не видят предметов, на которые они непосредственно смотрят, что делает невозможным просмотр телевизора, вождение автомобиля, распознавание знакомых лиц, прямые линии становятся «волнистыми», при чтении иногда некоторые буквы становятся невидимыми, снижается цветное зрение — все это нарушает обычный порядок жизни таких людей. Обычно ВМД обнаруживают случайно и, следовательно, слишком поздно, потому что мозг компенсирует начальные потери зрения. Боль, как признак того, что что-то не так, при данном заболевании отсутствует.
Возрастная макулярная дегенерация – прогрессирующее глазное заболевание, которое приводит к снижению остроты зрения за счет поражения центрального отдела сетчатки глаза – макулы (в ней, плотно прилегая, друг к другу, располагаются миллионы колбочек и палочек). Дегенерация макулы обычно поражает оба глаза, хотя и бывает асимметричной, то есть один глаз поражается больше, чем другой.
Существуют две формы ВМД: «сухая» (или атрофическая) дегенерация, которая возникает при понижении плотности пигмента макулы и может переходить во «влажную» (или экссудативную). Хотя «влажная» форма составляет всего около 10-20% от всех случаев ВМД, именно она часто является причиной слепоты. При этой форме заболевания со стороны сосудистой оболочки глаза начинается врастание новообразованных сосудов под сетчатку. Эти сосуды формируют субретинальную неоваскулярную мембрану. Пропотевание жидкости из неоваскулярной мембраны ведет к локальной отслойке слоев сетчатки и неизбежной гибели фоторецепторов — палочек и колбочек. Белковый экссудат, кровоизлияния усугубляют ситуацию, приводя к формированию грубого рубца в макуле и необратимому ухудшению зрения.
Факторы риска:

Чем старше становится человек, тем защитная система глаз становится все более уязвимой и требует дополнительной помощи. Наряду с возрастным фактором, являющимся «естественной» причиной ВМД, существует еще и группа риска по развитию данного заболевания.
Курение: у курильщиков риск заболеть ВМД в два раза выше, чем у некурящих. Причиной этого являются метаболические изменения, которые оказывают влияние на развитие ВМД. Курение приводит к образованию свободных радикалов. Курильщикам требуются более высокие дозы антиоксидантов, которые нейтрализуют свободные радикалы. Бросайте курить или сократите количество сигарет как можно скорее!
Несбалансированная диета: отсутствие или недостаток в диете необходимых витаминов и микроэлементов, а также защитных каротиноидов (лютеина и зеаксантина), ослабляет антиоксидатную систему организма.
Ожирение: Ученые обнаружили, что отложение двух важных веществ, лютеина и зеаксантина, осуществляется в жировой ткани и в макуле. Оба каротиноида (растительных пигмента) обнаружены в высокой концентрации в жировой ткани людей с избыточной массой тела, в то время как в тканях глаза их содержание было низким. Эту проблему невозможно решить путем увеличения потребления лютеина и зеаксантина. Только снижение веса может подготовить почву для успешного применения пищевых добавок.
Солнечная радиация и, прежде всего, синяя часть солнечного спектра является наиболее опасной для сетчатки глаза и может привести к частичной потере зрения. Функцию естественных «солнцезащитных очков» в нашем организме выполняют обнаруженные в сетчатке глаза каротиноиды — лютеин и зеаксантин (эти вещества могут поступать только с пищей, организм человека не в состоянии их вырабатывать). Они «фильтруют» синий свет и работают как антиоксиданты. Но с возрастом количество каротиноидов, которые являются частью антиоксидантной защитной системы, снижается.
ВМД может также быть результатом длительного воздействия света на сетчатку. При этом – как и при курении – происходит дополнительное и чрезмерное образование свободных радикалов, которые, в свою очередь, вызывают увеличение нагрузки на защитную систему, поэтому офтальмологи рекомендуют использовать для защиты глаз солнцезащитные очки.
Представители этнической группы: люди со светлой кожей и голубым цветом радужной оболочки глаз в большей степени подвержены ВМД.
Пол: женщины более подвержены ВМД, чем мужчины.
Наследственность: люди, имеющие случаи заболевания ВМД среди близких родственников.
Генетический фактор: в отдельных случаях комбинация генов является причиной ВМД.
Если один глаз поражен ВМД существует большая вероятность развития болезни и в другом глазу.
Патологический процесс при возрастной макулодистрофии течет индивидуально, однако при развитии субретинальной неоваскулярной мембраны временной фактор приобретает ключевое значение. При ранней диагностике этого состояния и своевременно начатом лечении можно избежать потери зрительных функций, добиться длительной ремиссии (временного затухания процесса) или его обратного развития.
В профилактике развития ВМД большое значение приобретает рациональное питание, включающие фрукты и зеленные овощи (капусту, перец, шпинат, брокколи, зеленый горошек, кукурузу), содержащие в большом количестве антиоксидантные витамины А и Е, каротиноиды и цинк, и употребление лютеинсодержащих добавок приводящее к увеличению концентрации лютеина в сыворотке крови и сетчатке.
Лечение:
Лечение ВМД включает: наблюдение, прием антиоксидантных витаминных и минеральных добавок, интравитреальные инъекции (в стекловидное тело) препаратов (Луцентис, Эйлеа, Визкью), ингибирующих (угнетающих, подавляющих) выработку эндотелиального сосудистого фактора роста (VEGF). Доказано, что при их введении в стекловидное тело прекращается рост сосудов, уменьшается экссудация, что способствует сохранению нервных клеток макулы. Луцентис вводится в стекловидное тело в строго определённой дозе. Операция выполняется обычно 3 раза с интервалом в 1 месяц. Контроль за состоянием макулы осуществляется с помощью оптического когерентного томографа (ОКТ) высокого разрешения. Луцентис стал первым лекарственным препаратом, лечение которым приводит не только к замедлению прогрессирующего снижения центрального зрения, но и к частичному восстановлению остроты зрения (повышение остроты зрения у 25-40% пациентов и ее стабилизация у 95%).
Ещё одним способ лечения ВМД является фотодинамическая терапия. Она основывается на внутривенном введении препарата под названием вертепорфин (Визудин), который, откладываясь в стенках сосудов сетчатки, избирательно повышает их чувствительность к лазерному излучению определенной длины волны. Таким образом, добивается целенаправленное действие на патологические новообразованные сосуды и уменьшается степень повреждения здоровых окружающих тканей. В тщательно проведенных сравнительных исследованиях ученые убедительно доказали, что при определенных формах влажной ВМД фотодинамическая терапия позволяет остановить прогрессирование болезни и добиться улучшения зрения.
Несколько советов пациентам:
Если Вам был поставлен диагноз возрастная макулярная дегенерация, это не повод уходить в болезнь. Вы можете, пусть ненамного, но улучшить своё состояние некоторыми простыми способами:
- Регулярно проверяйте свое зрение по решетке Амслера — это позволит вовремя обнаружить изменения в сетчатке, требующие лечения.
- Принимайте поливитамины с микроэлементами и лютеином — это доказано замедляет развитие заболевания.
- Включите в свой рацион листовые зеленые овощи: шпинат, листовую капусту, салат.
- На солнце всегда надевайте очки с защитой от ультрафиолетовых лучей.
- Бросьте курить. Курение нарушает работу сосудов, в том числе сосудов сетчатки.
- Не забывайте про физические упражнения — это приводит к общему оздоровлению организма и увеличивает эффективность работы сосудистой системы.
Пациентам Диагностика зрения Коррекция зрения Факичная ИОЛ Глазная хирургия Глазные заболевания Платные услуги Льготные группы Аптека Столовая и кафе Проживание Памятка пациенту Школа больного глаукомой График работы Общие правила госпитализации Документы в помощь пациенту Защита персональных данных пациентов Контактная информация Онлайн запись на прием Вопрос-ответ Задать вопрос специалисту Специалистам Конференции Хабаровского филиала Архив конференций Научная деятельность Хабаровского филиала Общество офтальмологов Научный отдел Оргметод отдел Офтальмологический кружок История офтальмологии Хабаровска Рекомендации по подготовке научных статей Клиника О клинике Система клиник МНТК Филиалы МНТК Лицензии О Федорове С. Н. Наши отделения Наше оборудование Охрана труда Профсоюзная организация Противодействие коррупции Отзывы о нас Контакты Контактная информация Онлайн запись на прием Оставить отзыв Задать вопрос специалисту
Единый информационный телефон 8 (4212) 25-27-37
680033, г. Хабаровск, ул. Тихоокеанская,211
Все права защищены.
© ХФ ФГАУ «НМИЦ «МНТК «Микрохирургия глаза» им. акад. С.Н. Федорова» Минздрава России 2009-2021 г.
Информация, представленная на сайте не является публичным договором
и носит информационно-ознакомительный характер.
Возрастная макулярная дегенерация (ВМД)

Возрастная макулярная дегенерация (ВМД, макулодистрофия, дистрофия сетчатки, дегенерация «желтого пятна») - это хроническое прогрессирующее заболевание заднего отрезка глаза, характеризующееся дистрофическими процессами в центральной зоне сетчатки и сосудистой оболочке глаза.
Почему развивается ВМД?
Одной-единственной причины развития макулярной дегенерации нет. Существует несколько причин, являющихся пусковым моментом заболевания. В этой связи принято выделять такие факторы риска развития макулодистрофии, как:
- возраст (средний возраст больных макулодистрофией колеблется от 55 до 80 лет;
- пол (женщины болеют в 2 раза чаще мужчин);
- наследственность (если прямые родственники страдают ВМД, то шансы заболеть увеличиваются);
- сердечно-сосудистые заболевания (артериальная гипертония, атеросклероз сосудов головного мозга);
- сахарный диабет;
- несбалансированное питание (избыточная масса тела, ожирение, высокий уровень холестерина в крови);
- курение;
- плохая экология;
- перенесенные заболевания или травмы глаз.
Как понять, что у меня начинается дистрофия сетчатки?
Как правило, на начальной стадии заболевания у пациентов страдает центральное и цветовое зрение: сначала происходит потеря яркости и контрастности цветов и искажение линий, затем возникают трудности при чтении и письме (выпадение отдельных букв и целых слов), позднее появляются жалобы на снижение остроты зрения как вдаль, так и на близком расстоянии.

Какие формы возрастной макулярной дегенерации существуют?
Выделяют «сухую» и «влажную» формы дистрофии сетчатки. «Сухая» форма встречается в 90% случаев. «Влажная» форма встречается значительно реже (приблизительно в 1 случае из 10), однако является более опасной.
Какие методы исследования применяются в диагностике макулодистрофии? Какой из них являются наиболее эффективным?
Среди многочисленных методов диагностики дистрофии сетчатки наиболее важными и эффективными являются: оптическая когерентная томография (ОКТ) и флюоресцентная ангиография сетчатки (ФАГ). На основании данных исследований наши специалисты смогут определить форму заболевания, его стадию и поставить точный диагноз.


Высокоэффективным тестом является также самоконтроль зрительных функций каждого глаза в отдельности по сетке Амслера. Если вы заметили любые изменения формы линий сетки (искривления, искажения, прерывистость и затуманивание, как в примере справа) немедленно обратитесь к врачу.

Как быстро будет прогрессировать возрастная макулярная дегенерация и что меня ожидает?
У большинства пациентов встречается «сухая» форма дистрофии, которая прогрессирует медленно, позволяя годами и даже десятилетиями сохранить относительно высокую остроту зрения. «Влажная» форма макулярной дегенерации характеризуется более стремительным течением, когда за несколько недель или месяцев происходит значительное снижение остроты зрения.
Какие методы лечения ВМД существуют?
К сожалению, в настоящее время нет эффективных способов, которые позволили бы полностью вылечить пациентов от ВМД и восстановить зрение. Во всех случаях терапия подбирается индивидуально и комплексно с учетом формы и стадии заболевания.
При «сухой» форме ВМД рекомендуется прием препаратов в форме таблеток, который пациент может осуществлять самостоятельно в домашних условиях. Однако для более эффективного лечения целесообразно введение препаратов в виде местных инъекций («под глаз»), а также внутримышечных и/или внутривенных назначений.
Совершенно иной механизм развития «влажной» формы ВМД определяет отличия в подходах к её лечению.
В настоящее время приняты следующие варианты терапии:
- интравитреальное («в полость глаза») введение ингибиторов ангиогенеза;
- лазерное лечение;
- комбинация вышеуказанных методов.
Что такое ингибиторы ангиогенеза?
Причиной снижения зрительных функций при «влажной» форме ВМД является прорастание новообразованных неполноценных сосудов в ткань сетчатки с последующим повреждением этой области. Препараты данной группы способны подавить рост патологических сосудов и остановить прогрессирование заболевания.

Накопленный многолетний опыт лечения названными веществами показывает, что для достижения максимального эффекта целесообразно трехкратное внутриглазное введение препарата с интервалом в 1 месяц. Дальнейшая тактика определяется результатами динамического наблюдения. При появлении новых признаков активности заболевания необходимо дальнейшее продолжение терапии ингибиторами ангиогенеза.
Лечением ВМД в «Леге Артис» занимаются
Ануфриев Сергей Иванович – врач-офтальмохирург, кандидат медицинских наук, врач высшей аттестационной категории;
Малафеев Александр Владимирович - врач-офтальмохирург, кандидат медицинских наук, врач высшей аттестационной категории;
Щербакова Галина Георгиевна – врач-офтальмолог высшей аттестационной категории;
Клембицкий Алексей Игоревич – врач-офтальмохирург.
Возрастная макулярная дегенерация
ВМД занимает одну из лидирующих позиций среди причин слепоты и слабовидения у взрослого населения. Среди факторов риска возникновения заболевания рассматриваются:
- возраст (превалирующий фактор риска, ВМД развивается у людей старше 50 лет, чем человек становится старше – тем вероятность возникновения заболевания выше);
- наследственность (люди, чьи близкие родственники страдают ВМД, подвержены большему риску возникновения этого заболевания);
- курение (повышает риск развития ВМД в 2 раза, имеется прямая зависимость между количеством выкуренных «пачко-лет» и риском возникновения ВМД);
- расовая принадлежность (европейцы больше подвержены возникновению ВМД);
- женский пол (у женщин ВМД развивается в более раннем возрасте, чем у мужчин);
- избыточная солнечная инсоляция (доказано повреждающее воздействие УФ-излучения на состояние сетчатки);
- среди дополнительных факторов риска рассматриваются: несбалансированное питание, ожирение, артериальная гипертензия, нарушения липидного спектра и др.
Симптомы ВМД
На ранних стадиях заболевания человек может не замечать никаких симптомов, но с прогрессированием заболевания могут отмечаться:

- резкое ухудшение зрения (выпадение букв, строчек при чтении, данное состояние не поддается коррекции очками);


Формы ВМД
Различают 2 формы ВМД: сухую и влажную.
Под сетчаткой располагается сосудистый слой (хориоидея), состоящий из множества сосудов различного калибра, участвующих в кровоснабжении сетчатки. При ВМД повреждения начинаются с самых наружных слоев сетчатки (пигментного эпителия и мембраны Бруха).

По мере старения в сетчатке накапливаются «продукты жизнедеятельности» глаза, называемые друзами сетчатки – друзы. Они представляют собой скопление желтоватого субстрата под пигментным эпителием сетчатки. Появление множества мелких друз или крупной друзы являются первыми признаками формирования сухой формы ВМД.
По мере накопления друзы могут запускать воспалительные процессы в сетчатке, в результате чего в ней вырабатывается эндотелиальный фактор роста сосудов (VEGF - Vascular Endothelial Grows Factor). Этот фактор способствует росту патологических новообразованных сосудов из хориоидеи под сетчатку. На этом этапе сухая форма переходит во влажную форму ВМД.
Стенки новообразованных хориоидальных сосудов несостоятельны и через них начинает пропотевать плазма крови, вызывая отек сетчатки. Они могут в любой момент разорваться и вызвать кровоизлияние под сетчаткой или в ее слоях. Скапливающаяся жидкость и/или кровь оказывают повреждающее воздействие на фоторецепторы сетчатки, что приводит к снижению зрения, появлению искривлений, искажений изображения. В случае несвоевременно оказанной помощи (или ее отсутствия) возникшее кровоизлияние может спровоцировать формирование рубцовой ткани, что приведет к необратимой потере центрального зрения (темное пятно перед глазом).
Диагностика
В случае возникновения вышеописанных симптомов ВМД следует в срочном порядке обратиться к офтальмологу.
Промедление с лечением ВМД может привести к необратимым последствиям. Возможна самодиагностика заболевания при помощи специального теста - теста Амслера. Это очень простой и быстрый способ выявления возрастной макулодистрофии. По сути, тест - квадрат, нарисованный на белом или черном фоне и состоящий из сетки с точкой посередине. По результатам теста можно определить у себя наличие или отсутствие макулодистрофии.
Тест Амслера
Тест Амслера проводится следующим образом:
- в хорошо освещенной комнате;
- сетка располагается на расстоянии 30 см от глаз (если вы используете очки для чтения, наденьте их);
- тест проводится отдельно для каждого глаза другой следует прикрыть ладонью;
- тестируемым (открытым) глазом зафиксируйте взгляд на центральной точке, далее, не отрывая взгляд от центральной точки, постарайтесь оценить ровность линий, форму и размеры квадратов, видимость сетки;
- повторите с другим глазом.

Если вы заметили, что где-то линии сетки искривлены, изогнуты, форма квадратов деформирована, размеры квадратов неодинаковые, имеются зоны выпадения в сетке, срочно обратитесь к офтальмологу.
Данные изменения могут быть признаками макулодистрофии (ВМД).
На приеме офтальмолог проведет необходимые обследования, включая проверку остроты зрения, измерение внутриглазного давления, осмотр переднего отрезка глаза и, главное - осмотр глазного дна. Также необходимо будет проведение оптической когерентной томографии (ОКТ - исследование, позволяющее получить изображение сетчатки, ее послойное строение с высоким разрешением) для визуализации структурных изменений, происходящих в сетчатке.
При необходимости врач назначит дополнительное обследование - флюоресцентную ангиографию (ФАГ – исследование микроциркуляции сетчатки путем внутривенного введения (как правило, в локтевую вену) специального контрастного вещества (флюоресцеина).

Лечение возрастной макулярной дегенерации
В вопросах лечения влажной формы ВМД важным фактором является своевременность оказания врачебной помощи. При промедлении эффективность проводимой терапии снижается, что, в конечном счете, может привести к потере центрального зрения.
Офтальмологи клиники Рассвет проведут все необходимые диагностические обследования. В случае подтверждения диагноза ВМД вам будут даны рекомендации по лечению, в зависимости от формы и стадии течения заболевания. Мы не назначаем курсы так называемого «поддерживающего лечения» сетчатки путем болезненных инъекций в/под глаза препаратов с недоказанной эффективностью. Все рекомендации по лечению и динамическому наблюдению за ВМД даются согласно общепринятым во всем мире стандартам ведения данного заболевания.
Начальные проявления сухой формы ВМД, как правило, не требуют лечения. Рекомендовано динамическое наблюдение за состоянием сетчатки.
Важно отказаться от курения, так как уже доказано, что курение повышает риск возникновения ВМД более чем в 2 раза!
Также рекомендуется придерживаться диеты, богатой антиоксидантами (витамин С, Е, каротиноиды), минералами (селен, цинк), Омега-3 жирными кислотами. К продуктам, которые их содержат, относятся: свежие фрукты и овощи, зелень, жирные сорта рыбы, молочные продукты (творог, сыр, молоко), орехи, бобовые.
Учитывая повреждающее воздействие повышенной солнечной инсоляции на сетчатку, рекомендуется максимальная защита глаз (очки со специальными УФ-фильтрами, головные уборы и другие средства защиты).
В случае дальнейшего прогрессирования заболевания (при более продвинутых стадиях сухой формы ВМД) для снижения рисков перехода во влажную форму возможно применение витаминно-минеральных комплексов с содержанием Лютеина, Зеаксантина, Омега-3 жирных кислот (согласно формулам AREDS 2, Age-Related Eye Disease Study 2).
Золотым стандартом лечения влажной формы ВМД являются инъекции в глазное яблоко (так называемые интравитреальные инъекции) специальных лечебных препаратов (ингибиторов ангиогенеза, anti-VEGF препаратов). Стандарт лечения – 3 загрузочные инъекции, которые вводятся с интервалом в 1 месяц первые 3 месяца. В дальнейшем необходимость повторных инъекций решается в индивидуальном порядке согласно течению заболевания и ответной реакции со стороны сетчатки.

Альтернативным видом лечения определенных видов влажной формы ВМД является фотодинамическая терапия (ФДТ). Суть лечения заключается в ведении в кровоток специального препарата (Вертепорфин/Визудин), который накапливается в патологических новообразованных сосудах. Под воздействием лазерного излучения происходит активация препарата в просвете патологических сосудов, что приводит к их «запаиванию».

Важно понимать, что в вопросе лечения влажной формы ВМД эффективность проводимой терапии определяется сроками оказания лечения.
И наоборот, промедление с лечением может привести к необратимой потере центрального зрения. Стоит разъяснить, что в случае ВМД речь не идет о полной потере зрения (полная слепота). При неблагоприятных исходах сохраняется периферическое зрение. Но отсутствие центрального зрения, несомненно, сказывается на его качестве, да и на качестве жизни в целом.
Как лечат ВМД в клинике Рассвет?
В зависимости от формы и стадии ВМД вам будут предложены рекомендации по уменьшению рисков прогрессирования заболевания, срокам динамического наблюдения, а также выбор предпочтительного варианта лечения в каждом конкретном случае. Мы не назначаем болезненные, а главное - бесполезные курсы «поддерживающего» лечения сетчатки (пара-, ретробульбарные инъекции препаратов с недоказанной эффективностью). Все рекомендации носят исключительно доказательный характер и входят в стандарты ведения возрастной макулярной дегенерации, принятые во всем мире.
Возрастная макулярная дистрофия
Бюджетное учреждение здравоохранения Омской области “Клиническая офтальмологическая больница имени В.П. Выходцева”

Время работы
ПН -ПТ 8:00 - 20:00
Вы здесь
Факты о возрастной макулярной дегенерации (ВМД)
Что нужно знать о ВМД
Что такое ВМД?
ВМД – это распространенное заболевание глаз, которое встречается у лиц 50-ти лет и старше, иногда ВМД страдают более молодые пациенты. ВМД представляет собой ведущую причину потери зрения у взрослых. Заболевание приводит к изменениям в макуле – части глаза, которая обеспечивает центральное и острое зрение, необходимое для четкого видения объектов.
В некоторых случаях ВМД прогрессирует настолько медленно, что зрение может не изменяться в течение длительного времени. В других случаях быстрое прогрессирование ВМД приводит к потере зрения на одном или обоих глазах. При снижении зрения возникают трудности в распознавании лиц, чтении, вождении машины, а также работе вблизи, например, шитье.
Макула состоит из миллионов светочувствительных клеток, которые обеспечивают острое и детальное центральное зрение. Это наиболее чувствительная часть сетчатки, которая локализована в заднем отделе глаза. Сетчатка быстро превращает свет в электрические сигналы и посылает их в мозг через оптический нерв. Затем мозг превращает электрические сигналы в картинки, которые мы видим. При повреждении макулы детали становятся видны нечетко.
Кто подвержен риску развития ВМД?
ВМД обычно развивается у лиц 50 лет и старше. С увеличением возраста риск развития ВМД повышается. Другие факторы риска включают:
· Курение. По данным исследований курение повышает риск ВМД в 2 раза.
· Семейный анамнез. Более высокий риск ВМД имеют лица, члены семьи которых страдают ВМД.
· Повышенная масса тела и ожирение.
· Наличие сердечно-сосудистых заболеванй.
· Работа с интенсивным источником света.
· Перенесенная операция по поводу катаракты.
Имеет ли значение образ жизни в развитии ВМД?
Некоторые особенности образа жизни, например, курение, связаны с риском развития ВМД несмотря на то, что неизвестно, насколько влияет на ВМД отказ от курения. Тем не менее, следующие компоненты здорового образа жизни могут влиять на развитие ВМД:
· Отказ от курения
· Физические упражнения
· Поддержание нормального уровня артериального давления и холестерина
· Здоровая диета, богатая зеленью, овощами и рыбой
Как диагностируется ВМД?
Ранние и промежуточные стадии ВМД, как правило, протекают бессимптомно. Помочь диагностировать ВМД может только тщательное исследование глаза с расширенным зрачком. Обследование включает следующие методы:
· Исследование остроты зрения. С помощью специальных таблиц определяется, как Вы видите на расстоянии.
· Исследование глаза с расширенным зрачком. Врач закапывает в глаза капли для расширения зрачков, что дает возможность лучше осмотреть задние отделы глаза. С использованием специальных увеличительных линз возможно лучше осмотреть сетчатку и оптический нерв для выявления признаков ВМД и другой патологии глаза.
· Сетка Амслера. Врач также может попросить посмотреть Вас на специальную сетку. Изменения центрального зрения могут приводить к исчезновению или искажению линий.
· Оптическая когерентная томография. Бесконтактный и безболезненный метод, позволяющий получить микроскопическое изображение сетчатки с четкой визуализацией ее элементов.
· Флюоресцентная ангиограмма. Для проведения этого вида исследования сначала проводится введение в вену контрастного вещества и по мере прохождения контраста по сосудам глаза, получают фотографии. Этот тест позволяет врачу выявить участки «протекания» сосудов и выбрать соответствующий вид лечения.
Вот вопросы, которые Вы можете задать своему врачу:
- Какой у меня диагноз и как пишется его название?
- Как лечится ВМД?
- Как это заболевание влияет на мое зрение сейчас и будет влиять в будущем?
- За какими симптомами мне следует наблюдать?
- Следует ли мне менять образ жизни?
Какие формы ВМД могут привести к потере зрения?
Выделяют две формы ВМД: сухая и влажная. Появлению влажной формы во всех случаях предшествует сухая.
СУХАЯ форма ВМД
Что такое сухая ВМД?
Сухая ВМД представляет собой наиболее частую форму ВМД. Она развивается у 90% пациентов с ВМД. При сухой ВМД происходит медленное разрушение светочувствительных клеток макулы с постепенным затуманиванием центрального зрения пораженного глаза. По мере прогрессирования ВМД Вы можете отмечать пятна в центре поля зрения. Ваш врач может назвать такое состояние «географическая атрофия».
Какими симптомами сопровождается сухая ВМД?
На ранних стадиях сухая ВМД имеет немного симптомов. Важно регулярно исследовать зрение до прогрессирования заболевания. На поздних стадиях наиболее частым симптомом сухой ВМД является затуманивание зрения. Объекты кажутся не такими яркими, как раньше. В результате, могут возникать затруднения в узнавании лиц, может требоваться больше света для чтения.
Сухая ВМД может наблюдаться на обоих глазах или первоначально может поражаться один глаз.
Что такое друзы?
Друзы представляют собой ранний симптом ВМД. Это оранжевые отложения под сетчаткой. Они могут быть как небольшими, так и крупными. Врач может выявить друзы при обследовании сетчатки с расширенным зрачком.
Сами по себе друзы не приводят к потере зрения. Но появление крупных друз представляет риск развития более тяжелой формы ВМД, которая, в свою очередь, приводит к тяжелому снижению зрения.
Стадии ВМД
· Ранняя ВМД. При ранней ВМД наблюдаются или мелкие друзы или небольшое число друз среднего размера. На этой стадии могут не наблюдаться какие-либо симптомы или снижение зрения.
· Промежуточная ВМД. На этой стадии могут выявляться друзы среднего размера или одна и более крупных друз. У многих пациентов также не наблюдаются симптомы. Некоторые отмечают появление размытого пятна в центральном поле зрения, некоторым может требоваться больше света при чтении и др.
· Поздние изменения при сухой ВМД. Наряду с друзами, при этой стадии может отмечаться разрушение светочувствительных клеток макулы с развитием так называемой «географической атрофии», что приводит к появлению размытого пятна в центральном поле зрения, которое с течением времени может увеличиваться и становиться темнее.
Может ли сухая форма ВМД перейти во влажную?
У всех пациентов развитию более тяжелой, влажной формы ВМД предшествовала промежуточная стадия сухой ВМД. Возможно быстрое развитие влажной ВМД даже при ранней стадии ВМД.
ВЛАЖНАЯ форма ВМД
Что такое влажная ВМД?
Влажной ВМД страдают 10% всех пациентов с ВМД. Однако эта форма является более тяжелой, чем ранняя или промежуточная стадия сухой формы.
При влажной ВМД происходит рост патологических сосудов под сетчаткой в области макулы. Вновь образованные сосуды характеризуются повышенной ломкостью и проницаемостью, что вызывает «протекание» жидкости и крови с развитием отека макулы и повреждением сетчатки.
Несмотря на то, что при влажной ВМД потеря зрения происходит быстро, существуют медикаментозные методы, которые позволяют остановить прогрессирование влажной ВМД и даже улучшить зрение, если лечение началось до выраженной потери зрения.
Какими симптомами сопровождается влажная ВМД?
Во время ранних стадий влажной ВМД может наблюдаться волнистость / искривление прямых линий, ухудшение зрения вдаль, «затуманивание», отсутствие резкости изображения. При влажной ВМД также может развиться «слепое пятно» с потерей центрального зрения. При чтении становится заметным искривление букв или строчек, выпадение букв.
При появлении этих симптомов нужно немедленно обратиться к врачу!
Читайте также:
